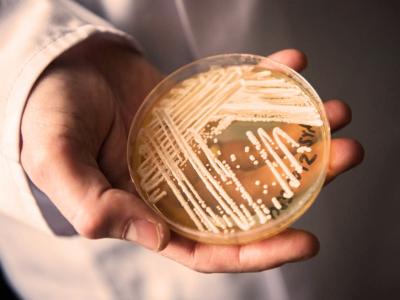
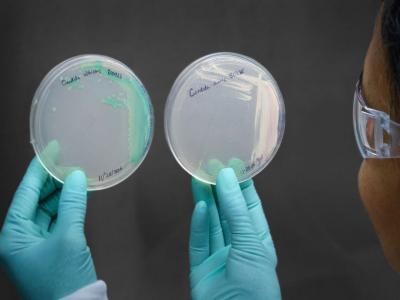

सावधान! जगात पसरतोय हा जीवघेणा व्हायरस, ९० दिवसांत मृत्यू अटळ
By ऑनलाइन लोकमत | Updated: April 9, 2019 19:41 IST2019-04-09T19:36:58+5:302019-04-09T19:41:16+5:30

जगभरात सध्या एक जीवघेणा व्हायरस रहस्यमय रितीने पसरतोय. या जीवघेण्या आजारावर कोणताच औषध नाही. माणसाचा मृत्यू हाच आजाराचा शेवट आहे. एका माणसाच्या शरीरातून दुसऱ्या माणसाच्या शरीरात हा व्हायरस शिरकाव करतो. या आजाराचं नाव आहे कैंडिडा ऑरिस

न्यूयॉर्क टाइम्सच्या अहवालानुसार आतापर्यंत कैंडिडा ऑरिस या आजाराने अनेकांचे जीव घेतले आहेत. या आजारामुळे इम्यून सिस्टम कमजोर करते
अहवालानुसार मागच्या वर्षी पहिल्यांदा कैंडिडा ऑरिस हा आजार असलेला रुग्ण ब्रुकलिन येथे सापडला होता. रुग्णालयात उपचार करत असताना एका वयोवृद्ध माणसाच्या रक्ताच्या नमुन्यात हा व्हायरस आढळून आला.

यूएस आणि यूरोपनंतर आता कैंडिडा ऑरिस आजार आशियाई देशातही हळूहळू पसरु लागला आहे. अहवालात सांगितल्याप्रमाणे भारत, पाकिस्तान, आणि दक्षिण आफ्रिका या देशातही हा आजार झालेले रुग्ण आढळून आले आहे.

यानंतर त्या माणसाला आईसीयूत ठेवण्यात आले. या वृद्धाच्या मृत्यूनंतर कैंडिडा ऑरिस या आजाराचे अनेक रुग्ण निदर्शनास आले. मागील पाच वर्षात व्हेनेझुएला आणि स्पेन येथे कैंडिडा ऑरिसचे अनेक प्रकरणं समोर आली. या कारणामुळे एक ब्रिटिश मेडिकल सेंटरला त्यांचे आईसीयू युनिट बंद ठेवावी लागली होती.
कैंडिडा ऑरिस या आजारावर कोणतेही औषध काम करत नाही. माणसाचा मृत्यू झाल्यानंतरही या आजाराचा व्हायरस आजारी रुग्णाच्या बेड, अंथरून, चादर, कपडे यात पसरलेला असतो.

कैंडिडा ऑरिस आजार हा सामान्य नागरिकांना माहिती नाही. या आजारावर उपचार करण्यासाठी औषध नाही म्हणून हा आजाराची माहिती लपवून ठेवल्याचंही सांगितले जात आहे.

कैंडिडा ऑरिस या आजाराबद्दल डॉ मैथ्यु मैककार्थी यांनी सांगितले की, ताप येणे, अंग दुखणे, शरीराची शक्ती कमी होणे त्याचसोबत इम्यून सिस्टम कमजोर करणे अशी लक्षणे रुग्णांमध्ये दिसून ययेतात सध्या या आजारावर औषधे शोधण्यासाठी संशोधन सुरू आहेत

















